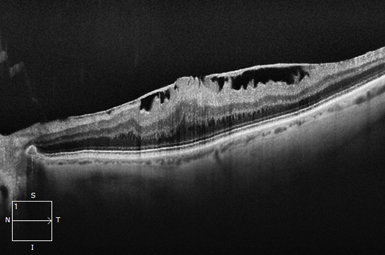

We understand your sight is precious. At High Country Macula, we exist to help you preserve and restore your vision.
The pathologies we treat.
Expert care for pathologic conditions of the Macula, Retina and Vitreous.
care.MACULA
The Macula is susceptible to many types of pathology. Early and aggressive treatment can typically help preserve or restore vision.

Macular Degeneration
There are two types of Macular Degeneration – Wet and Dry. If it becomes Wet, early intervention can usually preserve sight.
Macular Pucker
Numerous underlying conditions lead to scar tissue on the macula. When this affects vision, the scarring can be surgically removed.

Macular Hole
A Macular Hole creates a blank space in the central “film of your camera”. Surgical repair is typically highly successful.

Image courtesy of Carl Zeiss Meditec, Inc.
Macular Edema (CME)
Many eye conditions lead to macular swelling. Treatments include intravitreal injections, laser photocoagulation, periocular injections, and occasionally vitrectomy surgery.
care.Retina
Many disease conditions involve the Retina. Our highly trained specialists can help treat damage from these potentially blinding problems.

Image courtesy of Heidelberg Engineering, Inc.
Diabetic Retinopathy
Fifty percent of patients with Diabetes for 10 years exhibit some level of eye involvement. Aggressive treatment usually preserves vision.

Retinal Vascular Occlusion
Arteriosclerosis can lead to retinal blood flow problems and impaired vision. Injections, laser, and/or surgery frequently improve vision.

Retinal Tearing and Holes
Retinal defects can allow fluid to seep under, causing a Retinal Detachment. When treated early, this problem is usually preventable.

Retinal Detachment
This potentially blinding condition requires prompt surgical intervention. Successful reattachment usually preserves or restores visual function.

Retinoschisis
Retinoschisis can usually be safely observed. With associated holes or Detachment, however, it will require laser or surgical treatment.

Retinal Masses
Moles, (Nevi) of the posterior segment are common, and infrequently convert to Melanoma. Likewise, other eye tumors are rare.
care.Vitreous
Ageing of the eye is associated with Vitreous degeneration. When this leads to problems, our Physicians are trained to help.

Vitreous Hemorrhage
Vitreous Hemorrhage can be associated with many underlying conditions. It frequently clears on its own, but sometimes necessitates surgical removal.

Vitreo-macular Traction
Incomplete vitreous separation sometimes tugs on the macula. If non-resolving, surgery (or intravitreal medicine) usually rectifies this condition.

Vitreous Floaters
Many conditions cause vitreous floaters, but they typically occur with vitreous separation. Evaluation is required, with treatment depending upon etiology.
care.Inflammation
Inflammation of the eye (Uveitis) is a potentially blinding condition. Treated aggressively, however, the condition can typically be effectively managed.

Intermediate Uveitis
Intermediate Uveitis occurs when inflammation involves only the vitreous. Causes include Pars Planitis, and numerous infectious and inflammatory etiologies.

Posterior Uveitis
This represents Chorioretinal inflammation. It is caused by numerous types of infection and inflammation, and frequently requires medical therapy.

Pan-Uveitis
Pan-Uveitis represents inflammation of all eye layers. It requires a full evaluation, and frequently requires medical treatment and immunosuppression.

Endophthalmitis
Endophthalmitis is extremely uncommon, typically occurring after an invasive ocular procedure. It usually requires emergency antibiotic injections and sometimes surgery.
care.Trauma
When blunt or penetrating traumas threaten your sight, our Surgeons are on call at Albuquerque hospitals to assist you.

Ocular Trauma
Eyeball trauma causes inflammation, hemorrhaging, lacerations, and retinal tearing, or detachment. Emergency evaluation is required, with treatment based upon findings.


